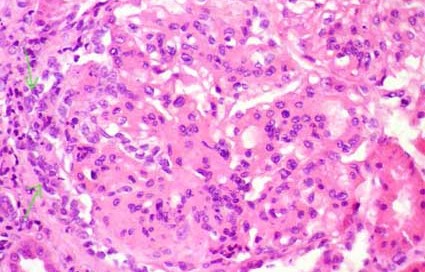

Diabetic Nephropathy
Diabetic kidney disease is the most common cause of kidney failure. 20-40% of diabetics get diabetic kidney disease. It typically occurs after 5 years of diabetes. Remember that the true duration of diabetes is often not known in patients with type 2 as the patient may have had the condition undiagnosed for a